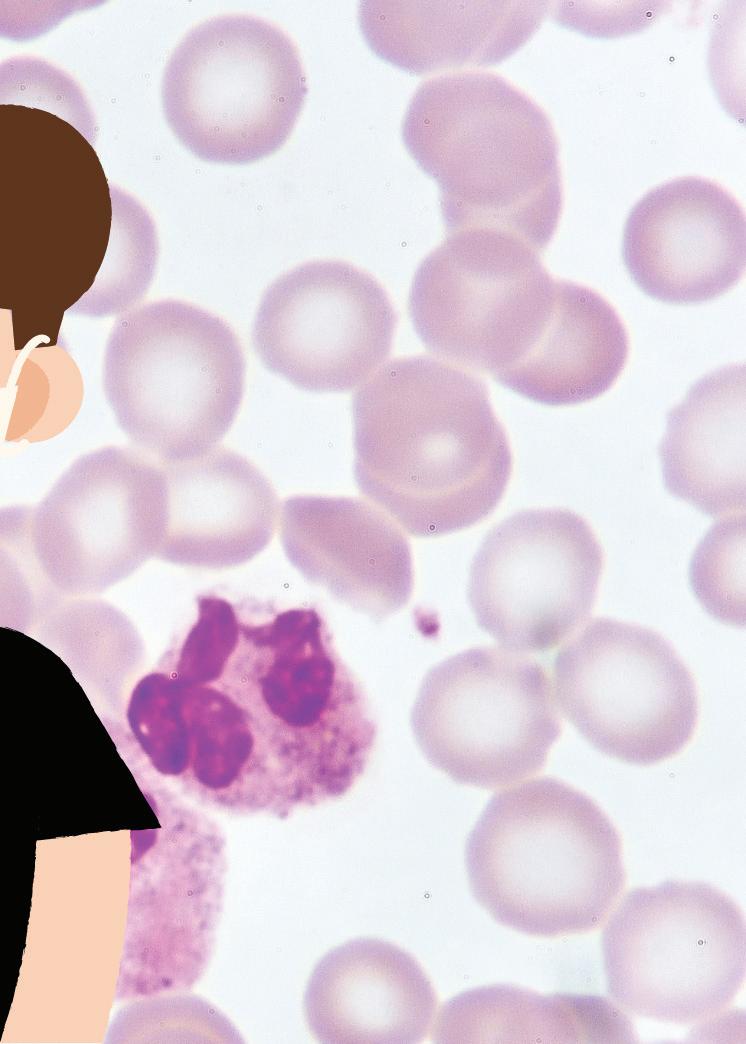
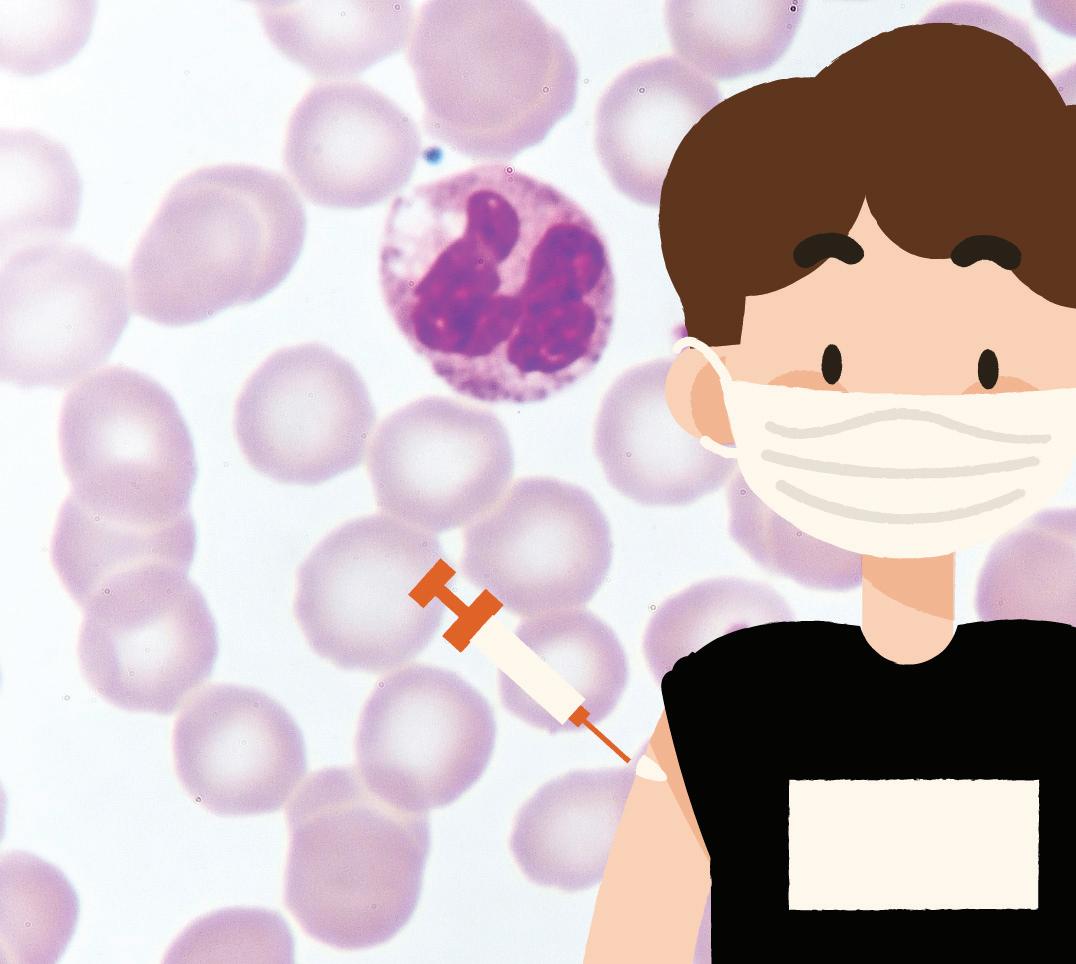

SJSU student organization fights houseless sweeps
By Alina Ta STAFF WRITER
Students Against Sweeps is a student-run campaign fighting against police sweeps by advocating for houseless people to be treated fairly in San Jose.
Sociology freshman Armando Guillen, a member of Students Against Sweeps, said the students involved in the campaign are pressuring city officials to use alternative solutions to decrease houselessness.

Students Against Sweeps is campaigning for the city to stop doing police sweeps and to find other alternative solutions.

The campaign was created as a part of sociology and interdisciplinary social sciences professor Scott Myers-Lipton’s sociology class.
Myers-Lipton said he invited Scott Wagers, pastor for the Community Homeless Alliance Ministry and co-founder of the Student Homeless Alliance, and other speakers to give students the opportunity to learn more about being more active in the community.
“The general idea of [it is] students come into the class and instead of just, like, taking notes and listening to lectures – the idea is that students still read books and read articles, but they [also] choose a campaign to work on. So about 50% of the class is the student campaign,” Myers-Lipton said.
Sweeps, referred to by the city of San Jose as “abatements,” are the forced disbanding of encampments on public property, including the removal of unhoused people and their respective property from that area, according to a Jan. 11
American Civil Liberties Union Washington article.
Wagers said during police sweeps they throw away or demolish houseless peoples tents and take their belongings.
“It’s, you know, inhumane and it’s a waste of money, waste of time,” Guillen said.
San Jose city officials cleared 606 tons of debris from 303 encampments in 2019, according to a March 3, 2021 memorandum from the city of San Jose.

The city carried out a sweep of a large houseless encampment near San Jose Mineta International Airport, according to a Sept. 2, 2022 article by SFGATE.
City officials cleared away vehicles, personal belongings and makeshift homes belonging to around 300 unhoused people, according to the same SFGATE article.
Wagers said many city officials resort to doing police sweeps in response to concerns from housed community members living near encampments.
Guillen said the city is spending millions of dollars doing police sweeps.
San Jose spent $1,084,619 on “encampment abatements,” another term for police sweeps, according to the city of San Jose memorandum.
The city of San Jose in 2019 also spent $4.85 million on police sweeps, according to a Dec. 2, 2021 San Jose Spotlight news article.

“Let’s say this week, this camp probably cost $10, $12 [up] to $14,000 just for one sweep,” Wagers said, referring to a houseless encampment in Roosevelt
Panel brings light to public safety issues, concerns
By Brandon Nicolas STAFF WRITER
San Jose’s non-profit news organization Spotlight held an event, “De-escalate,” a conversation on public safety with featured panelists that involved police and community organizers, on Wednesday at its headquarters.
The panelists included Santa Clara County Sheriff Bob Jonsen, Santa Clara Police Chief Pat Nikolai, community health advocate Darcie Green and community organizer Derrick Sanderlin.
The discussion started with Jonsen’s plan to reinstate the trust with the community, after former Santa Clara County Sheriff Laurie Smith was found guilty of six civil counts of corruption and willful misconduct, according to a Nov. 3, 2020 NBC Bay Area article.
“I think it’s really important in rebuilding that trust with the community,” Jonsen said.
He said the sheriff organization took several steps toward public safety in the community. One of the proposals was a psychological exam for people who apply for a concealed weapons license, as well as doubling the training requirement to receive a license to 16 hours.
Sanderlin said he led bias training with the San Jose Police Department during the beginning of the COVID-19 pandemic.
“There isn’t a way to measure the success of an implicit bias training and whether or not, it’s actually changing the culture of the department,” he said. “Except for brutality complaints and officerinvolved shootings, which happen every year.”
Sanderlin was shot with a rubber bullet by police during a protest on May 26, 2020 when attempting to de-escalate tension between protesters and police, according to a June 6, 2020 Los Angeles Times article.
Sanderlin said it is difficult to hold police officers accountable for their actions because of the arbitration
process and police union.
“Oftentimes, officers get reinstated or just moved to a different jurisdiction and continue putting on the uniform,” he said.
Anthony Mata, San Jose Police Department Chief, and the San Jose Police Officers’ Association declined the invitation to appear on the panel.
Green, who served on San Jose’s Community Safety Advisory Group, came up with 50 proposals regarding public safety.
“What I took away from that process was that our community doesn’t want safety that comes at the expense of black lives, brown lives, or immigrant lives,” Green said.
She said some of the group’s priorities included a community based response to interpersonal violence, decriminalizing houselessness and investments in safer street design.
“Like Darcie mentioned, there is more to policing than just police work,” Nikolai said. “We understand that and we want to reach out to the community and help them in any way that we can.”
Nikolai said one of the current plans for the department is the addition of crisis intervention specialists, officers who have special training to deal with mental health issues.
“We would love to get help from other people, but unfortunately, the police department is the one that is called,” Nikolai said. “Especially at 9 p.m. on a Friday night when there is someone having a mental health crisis with a handgun – they are going to call the police.”
Nikolai said, following the George Floyd murder in May of 2020, he and San Jose Mayor Matt Mahan created a diversity, equity and inclusion task force for the city of Santa Clara.
“Their mission was to review not only the police department, but the entire city to see if there are ways to make ourselves better,” Nikolai said.
Jonsen said it is important to
SERVING SAN JOSE STATE UNIVERSITY SINCE 1934 WWW.SJSUNEWS.COM/SPARTAN_DAILY Volume 160 No. 22 Thursday, Mar. 16, 2023 NAMED BEST CAMPUS NEWSPAPER IN CALIFORNIA FOR 2022 BY THE CALIFORNIA COLLEGE MEDIA ASSOCIATION
INFOGRAPHIC BY VANESSA TRAN SOURCE: NBC BAY AREA
ALINA TA | SPARTAN DAILY
STUDENT ORGANIZATION
| Page 2
SAFETY | Page 2
Scott Wager (left), founder of Community Homeless Alliance Ministry, and a collaborator pass out free clothes and shoes to a group of unhoused people on Monday at the encampment in Roosevelt Park.
SJSU experts analyze wage inequality
By Dominique Huber STAFF WRITER
Women in the United States have fought for equal pay since at least the 19th century. While some say the fight was over a long time ago, others say the gender wage gap is as present as ever.
The gender wage gap is the difference between how much money men and women make on average in relation to the median income of men, according to the Organization for Economic Co-operation and Development’s webpage.


Women in the U.S. earned 17% less than men in 2021, the seventh highest discrepancy out of 46 countries listed on the same Organization for Economic Co-operation and Development webpage.
Calculations of the gender wage gap in the U.S. are inaccurate and fail to take a number of factors into consideration, including occupation, rank and education level, according to a March 31, 2020 Forbes article.
The claim that women earn around 78 cents for every dollar men earn has been based on the average between every woman and man in the country, without regard to these distinctions.
For every dollar the average white man earned, Hispanic or Latina women made about 58 cents and Black or African American women made about 63 cents, according to a December 2022 report from the U.S. Government Accountability Office.
Patralekha Ukil, San Jose State assistant professor of economics, said there are two sets of data to look at when thinking about the gender wage gap – one adjusted and the other unadjusted.
Ukil said the unadjusted gender wage gap involves analysis of a broad set of factors, including education, work experience and race and ethnicity, resulting in the “statistics of 73 cents to a dollar or so” people often see.

She said the adjusted wage gap involves a more restricted analysis.
When looking at the adjusted wage gap, researchers also take into
SAFETY
Continued from page 1
account the type of job, industry and occupation, resulting in findings that show a more narrow discrepancy in pay.
She said the two main reasons for the gaps found in both analyses are personal choices and discrimination.
“Women tend to work in occupations where, like nursing, they are just in general paid less,” Ukil said. “But even when in the same occupation, if you just think about lawyers or MBAs, some of that gender pay gap could just be plain old discrimination.”
Ukil said women are more likely to take on the responsibilities of family and child care, choices which may lead them to take time off from work or turn down promotions that could affect their pay in the long run.
In a 2005 scholarly article published by Oxford University Press, researchers assessed the earnings of law school graduates.
The study examined two groups of students who graduated from law school at the same time and started out with very similar earnings.
After assessing the graduates’ earnings 15 years after leaving
implement mental health training into police departments across Santa Clara County, something he has been adamant about since his time as Chief in the Palo Alto Police Department.
“A psychiatric emergency response team is a team that puts an officer in the car with a mental health clinician,” Jensen said. “They respond to calls together to de-escalate those calls and provide the services needed.”
Jonsen said since 2021, there have been two response teams responding to over 300 mental health crisis calls and providing over 500 services.
Only one response led to an arrest.
law school, researchers found that the male graduates were earning 52% more than their female counterparts.
“Some of that could just be that these women were not getting promoted,” Ukil said. “It could also be that they’re making decisions based around the family. One way in which to sort of help that is to have more parental leave.”
There have been many theories about why the wage gap exists.
Angela Castillo, SJSU senior lecturer for the Women, Sexuality and Gender Studies program, said the explanation behind the wage gap is not black and white.
She said arguments which blame differences in pay on the individual choices of women don’t take into account a few crucial factors.
“They’re not taking into account the sexism and the patriarchal society that’s involved in the woman making that choice to do that job,” Castillo said.
She said beginning at a young age, many girls and boys have been socialized to take on certain roles in the family and to develop certain skills and interests.
Castillo said the roles that
Nikolai said well trained officers have all the tools necessary to de-escalate a situation and generally do not want to use force and would rather handle a situation peacefully.
“I think the answers about de-escalation was a little empty on the [Nikolai & Jensen’s] part,” said volunteer Kevin Aparicio. “In many instances we don’t see that in practice and can lead to violence and even death.”
Nearly 1,200 people were killed by police in last year alone, according to a 2022 Police Violence Report.
“I don’t think that we’ve normalized police violence . . . I think that we are deeply overwhelmed,” Sanderlin said. “If we continue to watch, we have to consider the psychological harm that comes to us – a lot of folks can’t bear to watch anymore.”
Follow the Spartan Daily on Twitter @SpartanDaily
– send a letter to the editor –
Letters to the Editor may be placed in the letters to the editor box in the Spartan Daily office in Dwight Bentel Hall, Room 209 or emailed to spartandaily@gmail.com to the attention of the Spartan Daily Opinion Editor.
Letters to the Editor must contain the author’s name, year and major. Letters become property of the Spartan Daily and may be edited for clarity, grammar, libel and length. Only letters of 300 words or less will be considered for publication.
Published opinions and advertisements do not necessarily reflect the views of the Spartan Daily, the School of Journalism and Mass Communication or SJSU. The Spartan Daily is a public forum.

women are often relegated to, such as professional nannies, are usually valued less and offered less compensation.
“Maybe years of training a girl or a woman to be nurturing would push her towards knowing how to be a nanny, and that would make her excel at doing that job,” she said.
Domestic work is a female-dominated field, with women making up around 90% of the workforce, according to a 2022 report by the Economic Policy Institute.
The median hourly pay for those workers is around $13.79, about 51% of them are people of color, according to the same Economic Policy Institute report.
Castillo said she attributes these types of patterns to the effects of certain institutions in American society.
“Men aren’t socialized throughout all these different institutions, such as the family, the education system or the government, to do those same roles,” she said. “And in fact they’re actually pushed out of those types of roles because people assume that men can’t care for children.”
Castillo said there are a number
of other explanations for why women make less money on average than men.
She said women are often expected to care for family and children without pay.
For women who began in the workforce and left to be caretakers, the time away from their career could be detrimental to their pay.
“When women go back into the workforce, they missed out on promotions and pay raises whereas their male counterparts are moving up,” Castillo said.
Forensic science senior Maryam Moshref said she expects to be affected by the gender pay gap in her career.
Females make up 78% of the student population in forensic science programs in the U.S., according to a study by researchers at Marshall University in West Virginia.
“To think that we are in 2023 and there still is a wage gap is literally astonishing because women are doing so much in the world,” Moshref said.
STUDENT ORGANIZATION
Continued from page 1
Park in Downtown San Jose.
He said this method is only a temporary solution.
Wagers said after city officials clear out houseless encampments, the people living in the camps either move across the street or back to the same location.
Sociology senior Angela Ramirez, a member of Students Against Sweeps, said the campaign is pressuring the city to follow their own promises.
“I wanted to also reiterate, [it] is our demand for the city [to follow] the abatement policy. They’re not following it,” Ramirez said.
The city would ensure those who are living in the encampments would receive the assistance and have their personal belongings properly managed, according to the same city of San Jose memorandum. The city also ensured the police sweeps would be done effectively and efficiently.
She said Students Against Sweeps have been using different strategies to pressure city officials to use more promising alternative solutions to decrease homelessness.
“So just by bringing awareness to it, and, you know, directly contacting the people that aren’t following [or] enforcing the policy, sending them emails, trying to reach out to them, things like that,” Ramirez said.
Guillen said Students Against Sweeps and another unhoused advocate are now trying to convince the city to donate one of their unused buildings to help the homeless.
She said the city passes out flyers at houseless encampments to let them know city officials will clear out their camps.
“They’ll serve these flyers and they tell them, ‘You know, we’re going to do a sweep here,’ and then weeks and weeks and weeks will go by and they won’t do the sweep,” Ramirez said. “So these unhoused people are living day to day not knowing if somebody’s going to come and kick me out of here.”
sjsunews.com/spartan_daily THURSDAY, MARCH 16, 2023 NEWS 2
Follow the Spartan Daily on Twitter @SpartanDaily
INFOGRAPHIC
BY RAINIER DE FORT-MENARES SOURCE: OECD
Follow the Spartan Daily on Twitter @SpartanDaily
BRANDON NICOLAS | SPARTAN DAILY
From left to right, Community Health Advocate Darcie Green, community organizer Derrick Sanderlin and Santa Clara County Sheriff Bob Jonsen discuss public safety at “De-Escalate” on Wednesday at San Jose Spotlight headquarters.
SJSU falls to Saint Mary’s at home
By Mat Bejarano STAFF WRITER

The San Jose State baseball team’s two-game winning streak ended Wednesday afternoon at Excite Ballpark, where the bats went silent with runners on base.

The firepower of the Spartans’ offense could not prevail against Saint Mary’s College, as SJSU lost 8-3.
Junior third baseman Dalton Bowling went 2-for-4 with a second inning homer while scoring two runs. Junior first baseman Hunter Dorraugh went 1-for-4 with a late eighth inning home run.
“Our guys know if we wanted a chance to get back in the game, it was right there,” Manager Brad Sanfilippo said. “I wasn’t super pleased with our effort today, we did have opportunities to flip that game a little bit.”
The Spartans came into the game outscoring their opponents 43-25 in total of their last five games.
Despite the 8 hits and 3 extra base hits, SJSU could not capitalize, as they left eight runners stranded.
Bowling’s home run in the second inning put the Spartans up 1-0 and the score looked to be the spark that set the offense up for the rest of the game.
“I just tried to stay balanced,” Bowling said. “I got a good pitch to hit and put a good swing on it.”
Bowling hit a double and later scored in the sixth inning that cut the deficit 4-2.
“You’re just trying to get the momentum back in our dugout,” Bowling said. “I trust every single one of the people in the dugout to score me and that’s
all I was just trying to do.”
Bowling is batting .326 and leads the team with 14 RBI’s.
Starting pitcher Aaron Eden came into the game with a 5.40 ERA in 15 innings pitched thus far this season.
Eden said he felt smoother on the mound than in previous outings.
“I just been working through some things, so I definitely felt good,” Eden said. “I definitely felt good, I felt in rhythm, I felt on time just with my delivery.”
Eden had his best outing of the season Wednesday, retiring all six batters he faced with no walks and one strikeout.
“I’m just looking to beat them,” Eden said. “Whether I have a strikeout, groundout, pop up, I was just looking to retire them.”
Sanfilippo said he took out Eden after two innings because it was a bullpen game for him and they wanted to restrict his pitch count.
“He was good and we obviously count on him to be one of our guys,” Sanfilippo said. “So it was good to see him throw the way he did.”
It would take six Spartan relievers to get through the game and the bullpen gave up 11 hits and 8 walks.
This included back to back
home runs by the Gaels in the bottom of the third and a two-run homer in the top of the fourth.
SJSU did not capitalize on crucial opportunities that included a bases loaded situation in the bottom of the fifth inning. The Spartans didn’t bring in the runs to tie the game down 4-1.
Hunter Dorraugh’s eighth inning home run cut the Gaels’ lead to 8-3, but SJSU could capitalize once again leaving two more runners stranded.
“I just was less than pleased with our effort today,” Sanfilippo said. “[I’m] not really upset with the outcome, I’m upset with how we went about it a little bit.”
Despite the loss, Sanfilippo said he still thinks the Spartans can turn it around.
“We haven’t really gotten into a rhythm of being able to capitalize on the momentum of playing well,” Sanfilippo said. “I’d like for us to be better this weekend.”
The SJSU baseball team is scheduled to play a three-game series against Air Force, starting at 12:05 p.m. on Friday at Excite Ballpark in San Jose.
sjsunews.com/spartan_daily THURSDAY, MARCH 16, 2023 SPORTS 3
BASEBALL
ENRIQUE GUTIERREZ-SEVILLA | SPARTAN DAILY
the Spartan Daily on Twitter @SpartanDaily
Junior third baseman Dalton Bowling hits a home run during Wednesday’s game against Saint Mary’s at Excite Ballpark.
Follow
Miley Cyrus prepares for summer
By Adrian Pereda SENIOR STAFF WRITER
While Miley Cyrus’s 2020 album “Plastic Hearts” was a snooze, “Endless Summer Vacation” is a breath of fresh air that contains experimental sounds with breezy contemplations and upbeat melodies.
“Endless Summer Vacation” came out on Friday and I cannot get enough of it.
Cyrus dives into her feelings regarding her divorce with actor Liam Hemsworth and gives listeners hits to bump during the summer.
Since her 2013 album “Bangerz,” I have been a stan of both her music and who she is as a person, from what I’ve heard and read about her career.
A stan is an overzealous or obsessive fan of a particular celebrity, according to the Oxford Dictionary.
“Flowers” and “Jaded” are just two of my favorite songs on her recent album, both of which revolve around love.
“Flowers” was an early release that caused controversy and made its way onto Billboard Global 200 for a reason.
A sampled hit from Bruno Mars’s 2013 recognizable song, “When I Was Your Man,” inspired “Flowers,” where she sings about being a strong woman and not needing a partner to do the things she enjoys.
“Jaded” is a strong follow up, delivering intense feelings for both parties of the failed relationship that gave a glimpse of what didn’t work when they were together.
Cyrus manages to look at both sides of the relationship and
admits she had some faults, but we can still blame Hemsworth for his cheating ways.
While the album includes 13 songs, it only two had features, “Thousand Miles” featuring Brandi Carlile and “Muddy Feet” featuring Sia.

I enjoyed them both as they contrasted each other.
“Thousand Miles” has more of a calm relaxing feel, while “Muddy Feet” is an angry bop in regards to infidelity.
If I had to choose, I would side with “Muddy Feet” because I enjoy more angry heartbreak songs.
As the album continues, Cyrus switches from her tragic love story to how she perceives herself and what it’s like to be on top.
“Island” is a three minute song that fills the listener in on her thoughts as a popstar in a different way than any other song on the album.
The entire song makes me feel like I’m sipping on a sex on the beach cocktail, until I actually start listening to the lyrics.
“Am I stranded (Am I stranded)/ On an island? (On an island)/ Or have I landed (Have I landed)/ In paradise?” got me in the sense where she talks metaphorically about being a stranger who’s lonely or seeing she has everything people want, money and excess fame.
album review
“Endless Summer Vacation”
Rating:
Artist: Miley Cyrus Release Date: March 10, 2023
Genre: Pop
Undeniably, I know Cyrus has the talent to write compelling songs and sing with her unique voice.
Even though she is mainstream, I fear she doesn’t have the power to stay as relevant with her music and is only known for her name now.
I loved this album as much as “Bangerz” and am a huge fan of hers, but I still sense that she’ll end up lost in my playlist.
I have a feeling her hype will
pass when comparing her to all of the other artists in my music frequently.
sjsunews.com/spartan_daily THURSDAY, MARCH 16, 2023 ARTS & ENTERTAINMENT 4 ACROSS 1. Pennies 6. Brown ermine 11. Hawaiian greeting 12. Leafy vegetable 15. Dealer 16. Deli dish 17. Strike 18. Stingy 20. Before, in poetry 21. Footnote note 23. Countless 24. Hotels 25. Amble 26. Young woman 27. Initial wager 28. Competition or combat 29. Beer 30. Distort 31. Bubbling over 34. Paired 36. Chapter in history 37. Small island 41. Mimicked 42. Russian emperor 43. Anagram of “Sale” 44. Pickpockets (slang) 45. Annoyance 46. Misplaced 47. Flowery verse 48. Fired from guns 51. South southeast 52. Not physically 54. Writer 56. Give one’s approval to 57. Primp 58. Direct 59. Dispatches DOWN 1. Large deer 2. The absolute superlative 3. Gesture of assent 4. Not us 5. Indian dress 6. Disdains 7. Add up 8. Follow orders 9. Stomach muscles, for short 10. Natural abilities 13. January’s birthstone 14. Flock members 15. Not 1st or 2nd 16. Continuously 19. Tiny 22. Expunges 24. First 26. Extol 27. Barley bristle 30. Rip 32. Sleeping platform 33. Angered 34. Unmarried 35. Adds on 38. Very drunk 39. Units of instruction 40. Aromatic compound 42. Bank employee 44. Covered stadium 45. Throb 48. Naked 49. Faucets 50. Certain 53. Youngster 55. 5 plus 5 7 2 1 4 5 4 3 7 6 6 9 6 6 1 8 8 4 2 7 2 4 8 7 9 9 CLASSIFIEDS CROSSWORD PUZZLE SUDOKU PUZZLE Complete the grid so that every row, column and 3x3 box contains every digit from 1 to 9 inclusively. AROUND “What do you PLACE YOUR AD HERE SOLUTIONS 5 3 8 39 8 2 1 3 2 2 5 5 6 4 1 9 7 8 8 9 7 4 9 5 7 6 1 17 4 9 3 7 2 3 1 1 2 3 2 4 5 9 4 8 3 4 7 3 7 6 5 4 6 4 4 8 6 1 2 8 2 8 13 9 6 9 5 6 7 6 9 7 8 1 2 5 3 5 DCENTSHASTOATSK AALOHAATCABBAGE TRADERRCOLESHOW HITEMISERLYUERE IBIDDOMANYAINNS ROVEALASSFANTEE DUELLALEATWISTR LUNEBULLIENTGOG AMATEDOERAGISLE PAPEDATSAREALES DIPSOPESTONLOST ODEEBULLETSOSSE MENTALLYUAUTHOR ENDORSEASPREENE DASTEERKESENDSR AGLETPSOONPCLA NOISEOPAGEAYALE ARENAMOREONBRIE LEDERHOSENGEGAD FINSGUNICACRESS SCREAMUSATANMPE TOILSABAGATELLE ALOEALIBELNTIED RATCHETEDNSINAI WERTOERRACCENT TTIREDHAERRLAPS DADOCNESMONGER ANONAERASELEAVE UGLIMSIREFLAMIA BOSCESETSTSPEL
ALBUM REVIEW Follow the Spartan Daily on Twitter @Spartandaily
ILLUSTRATION BY HANNAH GREGORIC
Jeremy’s Campaign: YouTubers to watch
By Jeremy Martin SENIOR STAFF WRITER
When I was younger, YouTube was my favorite site to look up videos about my favorite video games and systems.
The site would literally keep me entertained for hours, and it’s still one of my favorite things to do today.
Over the years, I have watched a plethora of different content creators in the video game community.
Anyone who watches YouTubers like this can probably relate to me.
Sit back, relax and let me introduce you to some new creators on the platform. Here are my Top 5 YouTubers in the video game community.


No. 5 on my list goes to two different creators. I counted both of these creators in one entry on my list because they are often talked about together.
In fact, one was inspired by the other. I’m talking about Chris Bores from Chris NEO and James Rolfe from Cinemassacre.
Chris NEO and Cinemassacre are just the names of their YouTube channels. They are known most commonly on YouTube for their shows “The Irate Gamer” and “The Angry Video Game Nerd.”
Bores and Rolfe have been making angry reviews of retro video games since the early 2000s.

Most of their videos consist of themselves making outrageous reviews of old video games and blowing their criticisms out of proportion for comedic effect.
Rolfe made his first couple of reviews in 2004 on Castlevania II: Simon’s Quest and on Dr. Jekyll and Mr. Hyde for the Nintendo Entertainment System.
He decided to continue the series on the same system with a review of The Karate Kid in 2006, according to Fandom.
Bores wanted to try his own hand at this new angry reviewer genre on YouTube, after seeing Rolfe popularize the genre back in 2007.
He created his own channel where he posted his first angry video game review on Back to the Future on the Nintendo Entertainment System, according to Fandom.
Both creators have been going strong ever since and even crossed over with a collaboration video on YouTube in 2020.
The nature of these angry reviews between both creators would keep any fan of retro video
games or video games in general entertained and laughing for hours.
For anyone who would prefer different content, both these creators have more under their belts too.
Rolfe often makes videos about different films and its history, as he’s very interested in the subject.
Bores also has a series on YouTube called “Irate The ’80s,” where he discusses different pop culture-related topics from the decade.
Metal Jesus Rocks is the name of another respected YouTuber and channel in the video game community.
Jason Lindsey or Metal Jesus Rocks is known for primarily making videos about retro video games.
However, he often covers a variety of topics within the video game community.
Lindsey has done videos about the art of successfully haggling prices for video games, what the best HDMI solutions are for older consoles to plug into modern TVs and even his own experience of video game hunting around Japan.
He has a large group of friends who are also content creators on YouTube and commonly appear in his own videos, commonly referring to them as the “Metal Jesus Crew.”
His crew consists of individuals such as Kinsey Burke, Kelsey Lewin and John Riggs.
Lindsey doesn’t just talk about video games, but he also has videos about music because he collects vinyl records.
He tends to maintain a familyfriendly PG environment on his channel, straying away from showing as much profanity and crude content as possible.










Raychul Moore is a YouTube content creator whose channel bears the same name.

She’s a perfect example of a girl who loves happy adorable things even if she can also kick your ass in just about any video game.
Don’t let her appearance fool you, she is just as knowledgeable and well-rounded in the community as any guy.
Moore used to be a video game journalist, writing for different publications such as GamePro and a website called GameGirl, according to her website.
She then transitioned to more on-camera work for different video game-based websites. Today, she manages her own
gaming-oriented YouTube channel and also cosplays on the side.
On her channel, Moore often talks about plenty of topics within the community, posts reviews and creates various top 10 lists of her favorite things in video games.
She’s the perfect creator to follow for anyone who loves modern video games and talks about the latest topics in the industry.
Moore’s living proof that guys definitely aren’t the only ones who know their video games.
The Game Chasers is a YouTube duo made up of both Jay Hatfield and Billy Hudson, according to Fandom.
Known as Shady Jay and Billy Chaser on YouTube, these two manage a channel where they go around looking for retro video games.
They drive all around their home state of Texas and other various locations.
The dynamic duo are constantly on the lookout for thrift stores, yard sales, garage sales and flea markets to find various video games.
They even go to their favorite retro video game stores as well.
Their videos are both entertaining and memorable, as they usually collaborate with other creators.
Fellow content creators like
the same channel called “The Toy Chasers.”
The initial inspiration for their show “The Game Chasers” came from the popular television series “American Pickers,” according to Fandom.
“American Pickers” is a History channel program about searching junkyards, barns, basements and garages in search of various antiques, according to the History channel’s website.
The Game Chasers is a perfect YouTube channel for anyone into retro video games or video games alike. The show will get those nostalgic video game juices pumping for anyone who grew up in the ’80s, ’90s and even the early 2000s.
Coming in at No. 1 on my list is the Gaming Historian.
Norman Caruso, otherwise known as The Gaming Historian, is a YouTuber who creates content explaining the events of different milestones in video game history, according to his website.
The name of his channel comes from the fact that he gives the viewer a “history lesson” in each video about different milestones in gaming history. He thoroughly explains
how these events happened and their effects throughout video game history.
He has a variety of videos explaining major events, including the creation of the Entertainment Software Ratings Board, the creation of games like Super Mario Bros. 3 and video game peripherals such as the Gameboy Pocket Sonar.
This channel is No. 1 on my list as I believe it is the most universally interesting out of all the other channels on this list. Caruso does a good job of making both interesting and engaging videos.
He makes sure that video game enthusiasts and non gamers can both enjoy his content. I also believe that, out of all the channels listed, this would be the most interesting to the San Jose State community.
Caruso often covers milestones from video games that are made by companies that have its headquarters in the heart of Silicon Valley.
Therefore, I would consider his content to be the most interesting and deserving of the No. 1 spot on my list for the best YouTube content creators in the video game community.
AlphaOmegaSin, Gaming Historian and Gamster81 often join them in their efforts.
ning and memorable, as ally collaborate with eators w content megaSin, Historian mster81 n them in their ately, the duo aims to nd long with other items of with a second show on
Ultimately, the duo aims to collect and preserve retro video games, along with other items of the past, with a second show on
sjsunews.com/spartan_daily THURSDAY, MARCH 16, 2023 ARTS & ENTERTAINMENT 5
COLUMN
GRAPHIC BY VANESSA TRAN
ILLUSTRATION BY SAM DIETZ Follow the Spartan Daily on Twitter @SpartanDaily
Ke Huy Quan’s win calls for more representation
By Christine Tran STAFF WRITER

Nothing could warm my heart the same way Ke Huy Quan did when he won the Oscar for best supporting actor on Sunday.
Quan was given the Oscar for his role as Waymond Wang in “Everything Everywhere All at Once,” where he played Michelle Yeoh’s character Evelyn Wang’s husband.
“Everything Everywhere All at Once” is a 2022 science fiction film about Evelyn, who is stuck in a time loop until she realizes she can travel through parallel universes. The film took home seven Oscar awards out of 11 nominations.
Quan is already a recipient of a Golden Globe, a Screen Actors Guild Award and an Academy Award among others yet he is so humble.
On his Instagram, Quan frequently posts selfies with celebrities pointing at them in awe.
is the first actor of Vietnamese descent to win an Oscar at all, which is huge news.
Quan’s portrayal of Waymond Wang is the opposite of what’s required from leading men, especially ethnic men, in movies and TV shows these days: young, hot, macho. His character stands out to me because Asian people deserve to be represented in all stages of life. If actors like Harrison Ford are still booking roles, the doors should be open for older Asian actors too.
I remember being so happy when Marvel Studios released “Shang-Chi and the Legend of the Ten Rings” in 2021 with Simu Liu as the leading superhero. I even vowed to see it multiple times because an Asian superhero was finally given a standalone movie in a film media franchise that I love.
Don’t get me wrong, I enjoy watching a majority Asian American cast in recent movies, but it seems that Asian
girlfriend’s family than they do about his character, Bob. His only personality trait is in the title of the movie.
Hollywood continues to produce movies centered around Asian characters and their martial arts skills because of this.
It pushes a harmful stereotype that this is the full Asian experience, while I’ve never taken a kung fu or karate class a day in my life.
You’re telling me in a huge universe that is in Marvel Cinema, the best superpower the writers could come up with for Shang-Chi is martial arts?
Also, why did Liu’s character have to be named Shang-Chi? Why couldn’t his name be Steve like Captain America or Tony like Iron Man?
villain. Even worse, I thought that Asian American actors could only star in films where the plot is centered around race. I want to see Asian actors in more leading roles that are written for anyone to portray, especially movies with an original script. There is nothing stopping them from doing so except the box that Hollywood has restricted them to.
Quan’s return to the big screen is iconic and shows that there are talented Asian male actors past the age of 35 who don’t have washboard abs and that’s okay.
As a fellow Vietnamese American, it was refreshing to see Quan tackle a complex character in a genre like science fiction.
actors star in new movies that defy lazy writing, now that “Everything Everywhere All at Once” proved itself as a critically acclaimed success.
Per Quan’s recent Instagram post, he expressed his love and gratitude for his Oscar win from the Academy.
Although Quan’s return was remarkable, Hollywood has built a bad habit of casting the same Asian American actors instead of letting new, diverse actors take the stage.


Can someone please remind this precious man that he’s also famous?
I have never seen Quan in his films from the 1990s like “Indiana Jones” or “The Goonies,” but after a 25-year-break from the casting industry, I believe his comeback role was a powerful representation for Asian Americans.
It led to Quan being the first Asian actor to win an Oscar in this category in 38 years and he
actors are still casted based on harmful stereotypes.
Even though I adored ShangChi, there were still aspects of the film that were problematic.
Growing up, the only Asian representation I had on television was Jackie Chan, who did his own dangerous stunts in every single movie he starred in.
Despite the fact that Chan is the lead character in “The Spy Next Door,” the audience knows more about his
And don’t even get me started on the dragon fight scene towards the end of the movie. Another recent movie with an all Asian cast was “Crazy Rich Asians” in 2018 and the title just speaks for itself. While I am a sucker for romcoms, and Singapore was absolutely beautiful to see on screen, it bothered me how Nick’s disapproving mother, Evelyn, taunted and bullied his girlfriend Rachel until the end of the movie.
Portraying Asian people as evil in small, one-dimensional roles reinforces the stereotype that they will always be different from Americans. This is harmful because it limits roles in media for Asian American actors since audiences are only used to seeing them in that narrative.
Up until I watched “Everything Everywhere All at Once,” I truly believed that people who look like me could only attain roles where they are either a martial artist or the
He played a co-owner of a laundromat, and in terms of the Asian American immigrant experience, that is more realistic to me than turning into a dragon or meeting your boyfriend’s powerful and rich family in Singapore.

I hope to see more underrated Asian American
“I hope that everyone who watched on Sunday night will find hope in our wins because the impossible was just made possible,” Quan said in the post. “Although it took a long time to get here, I would not have changed a thing. I never thought that I would be in a position to inspire others.”
sjsunews.com/spartan_daily THURSDAY, MARCH 16, 2023 ARTS & ENTERTAINMENT 6
OPINION
GRAPHICS BY VANESSA TRAN
the Spartan Daily on Twitter @SpartanDaily
Follow
I want to see Asian actors in more leading roles that are written for anyone to portray, especially movies with an original script. There is nothing stopping them from doing so except the box that Hollywood has restricted them to.
Everyone should get the vaccine booster
my shoulders. More importantly, it felt great to protect the two other immunocompromised people I lived with.
Living during the time of COVID-19 was also immensely scary as I didn’t really know the full extent of how the virus could affect people. All I knew was that I didn’t want to be the reason that one of my family members got the virus and ultimately died.

I got my first two shots of Pfizer in March of 2021, and once October rolled around, I knew it was time to get my booster.
The booster shot didn’t go how I expected as the day after I felt the side effects much stronger than my previous two shots, but my heart rate was way beyond the level that it should have been.
When I got home from work, I immediately went to bed, but could not stay asleep as my heart was just beating rapidly.
I left six hours after the nurses told me my heart was inflamed from a side effect of the booster vaccination shot.
I was diagnosed with Myocarditis, a rare condition in which inflammation occurs in the middle muscle layer of the heart, according to an American Heart Association article.
Leaving the hospital, I grew very worried about what decision I was going to make when it came time again to get another booster shot.
Myocarditis is a rare side effect for those receiving any COVID-19 vaccine, and in a case study of 1.4 million people, nine patients developed it, according to a Nov. 1, 2022 American Heart Association article.
When word began to spread about what had happened to me, my biggest fear started to become a reality as my close friends and family began to use my case as an example of why they did not want to receive a booster vaccination.
COVID-19 vaccination.
With the pandemic seemingly neverending, vaccination talk has started to slow, especially with a majority of the American population being vaccinated.
81% of Americans have received at least one dose of the vaccine, while 69% are considered to be fully vaccinated, according to usafacts.org
I understand that it can be scary to get vaccinated. Not everyone is able to get vaccinated due to medical or religious reasons, but those who can, and are willing, should not put those around them in danger.
Washington Wizards forward Bradley Beal initially refused to get vaccinated for personal reasons, according to a Sept. 27, 2021 Forbes article.
“I would like an explanation to people with vaccines, why are they still getting COVID?” Beal said in a Sept. 27, 2021 ESPN article. “Some people have bad reactions to the vaccine. Nobody likes to talk about that.”
The initial joy of being home for two weeks quickly faded as I soon realized how much the coronavirus lock down would affect my life.
Getting vaccinated can be a strange and uneasy feeling to some, but it plays an important part in protecting those around you.

As the three-year mark of the initial lockdowns approaches, it’s still important to advocate for people to get vaccinated and for those who are already vaccinated to receive boosters.
When the vaccines were rolling out towards the end of 2020, I knew that when I got the opportunity, I was going to take the shot no questions asked.
I knew that being vaccinated meant I was at less risk of getting COVID-19 and I could slowly return to working and going to school in person.
The most important part was that getting vaccinated not only protected myself, but it would protect my close family and friends.
As someone who is immunocompromised, it felt almost as if a weight was being lifted off of
I eventually measured my heart rate to see my resting heart rate at 140 beats per minute.
The average resting heart rate for most adults should sit at 60 and 100 beats per minute, according to an American Heart Association article.
I knew I had to go to the emergency room, and once I was there, the nurse initially thought that I had a blood clot in my lung, causing my heart to work overtime.

I felt sad what happened to me was now being used as a reason not to get vaccinated.
Even for myself, it was a very scary experience to have to get re-boosted because I was nervous that what happened to me prior would happen again.
After conversations with my primary health physician, I decided it was in my best interest and best interest of those who I live with to get my fourth
Beal would ultimately get vaccinated, citing not wanting to put his family in harm’s way, but said he still has questions about the vaccine, according to Dec. 30, 2021 NBC Sports article.
As someone who had negative side effects, I understand where Beal is coming from, but side effects shouldn’t deter people from getting vaccinated.
It’s our civil duty to those around us to get vaccinated if you can, and as the years progress, we will continuously need to get vaccinated even if we already have received COVID-19 vaccines prior.
Please don’t let bad side effects deter you from getting vaccinated, as one day of not feeling well outweighs the possibility of putting a loved one in harm’s way.
sjsunews.com/spartan_daily THURSDAY, MARCH 16, 2023 OPINION 7 EDITORIAL STAFF EXECUTIVE EDITOR NATHAN CANILAO MANAGING EDITOR ALESSIO CAVALCA ASSOCIATE EDITOR BOJANA CVIJIC PRODUCTION EDITOR CAROLYN BROWN NEWS EDITOR RAINIER DE FORT-MENARES A&E EDITOR VANESSA TRAN OPINION EDITOR JILLIAN DARNELL CONTACT US EDITORIAL –MAIN TELEPHONE: (408) 924-3821 EMAIL: spartandaily@gmail.com ADVERTISING –TELEPHONE: 408-924-3240 ADVERTISING STAFF ADVERTISING DIRECTOR MIA WICKS CREATIVE DIRECTOR BRIANNE BADIOLA ABOUT The Spartan Daily prides itself on being the San Jose State community’s top news source. New issues are published every Tuesday, Wednesday and Thursday throughout the academic year and online content updated daily. The Spartan Daily is written and published by San Jose State students as an expression of their First Amendment rights. Reader feedback may be submitted as letters to the editor or online comments. SOCIAL MEDIA EDITOR BRYANNA BARTLETT PHOTO EDITOR ALEXIA FREDERICKSON COPY EDITORS CHRISTOPHER NGUYEN GRAPHICS EDITORS HANNAH GREGORIC JANANI JAGANNATHAN MYENN RAHNOMA SENIOR STAFF WRITERS ADRIAN PEREDA JEREMY MARTIN OSCAR FRIAS-RIVERA STAFF WRITERS ALINA TA BRANDON NICOLAS CHRISTINE TRAN DYLAN NEWMAN DOMINIQUE HUBER ENRIQUE GUTIERREZ-SEVILLA MAT BEJARANO MATTHEW GONZALEZ PRODUCTION CHIEF MIKE CORPOS NEWS ADVISER RICHARD CRAIG EMAIL: spartandailyadvertising@gmail.com CORRECTIONS POLICY The Spartan Daily corrects all significant errors that are brought to our attention. If you suspect we have made such an error, please send an email to spartandaily@gmail.com. EDITORIAL POLICY Columns are the opinion of individual writers and not that of the Spartan Daily. Editorials reflect the majority opinion of the Editorial Board, which is made up of student editors.
Mat Bejarano STAFF WRITER
ILLUSTRATION BY VANESSA TRAN
Follow the Spartan Daily on Twitter @SpartanDaily
It’s our civil duty to those around us to get vaccinated if you can, and as the years progress, we will continuously need to get vaccinated even if we already have received COVID-19 vaccines prior.
Even after having bad side effects from the COVID-19 vaccine, I’m still getting another booster.